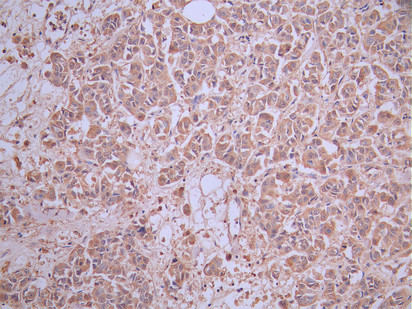
CSB-RA004935A0HU IHC

新興免疫檢查點SIGLEC15:突破PD-1耐藥的新希望
日期:2025-11-04 17:30:35
SIGLEC15是一種新興的免疫檢查點分子,廣泛表達于多種腫瘤中,與免疫逃逸、治療耐藥及不良預后密切相關。其通過抑制T細胞活性、誘導非炎癥性腫瘤微環境及調控腫瘤相關巨噬細胞極化,在腫瘤免疫抑制中發揮關鍵作用。近年來,針對SIGLEC15的單抗、雙抗、CAR-T細胞及基因沉默策略快速發展,為克服PD-1/PD-L1治療局限提供了新思路。本文在梳理SIGLEC15的結構與功能基礎上,系統分析其信號通路、疾病相關性及藥物研發進展,為后續免疫治療研究與新藥開發提供理論依據。
1. SIGLEC15研究的興起與意義
免疫檢查點抑制劑的問世推動了腫瘤治療革命,但仍有大量患者對PD-1/PD-L1療法無應答或出現繼發耐藥。尋找新的免疫調控靶點成為免疫治療升級的關鍵方向。Sialic acid binding Ig-like lectin 15(SIGLEC15)作為Siglec家族成員,憑借其獨特的免疫抑制功能和在多種腫瘤中的高表達,正逐漸成為下一代免疫檢查點研究熱點 [1,2]。
研究表明,SIGLEC15在多種腫瘤類型中高表達且與不良預后密切相關。與PD-L1不同,SIGLEC15的上調常出現在PD-L1陰性或免疫冷腫瘤中 [1-3],提示其可能通過獨立途徑介導腫瘤免疫逃逸。因此,深入解析SIGLEC15的作用機制及靶向策略,對改善腫瘤免疫治療響應具有重要意義。
2. SIGLEC15的生物學特征與表達模式
SIGLEC15是Siglec家族的重要成員,由胞外免疫球蛋白樣結構域、跨膜區及胞內短尾結構組成。其胞外結構可識別唾液酸化糖鏈,參與細胞間信號調控 [4]。胞內區雖不含典型的免疫抑制基序(ITIM),但可通過跨膜段與適配蛋白如DAP12形成復合物,從而介導下游信號 [5]。
研究顯示,SIGLEC15在肝細胞癌 [4]、甲狀腺癌 [6]、結腸腺癌 [1]、膠質瘤 [8]、膀胱癌 [2]及B-ALL [7]等多種惡性腫瘤中顯著上調。其高表達常與CD8+ T細胞浸潤減少、免疫抑制性細胞增加及總體生存率下降有關。免疫熒光研究發現,SIGLEC15與M2型巨噬細胞標志物CD163共定位,提示其在腫瘤免疫微環境中調控巨噬細胞極化過程 [8]。
3. SIGLEC15在腫瘤微環境中的作用機制
3.1 抑制T細胞功能
SIGLEC15通過抑制CD8+ T細胞活性、降低細胞毒性及影響其生存能力來實現免疫抑制。其高表達常與趨化因子(如CXCL9/10)減少及T細胞炎癥評分下降相關 [10]。在B-ALL模型中,敲除SIGLEC15可促進CD8+ T細胞擴增并增強抗腫瘤免疫應答 [7]。
3.2 與腫瘤相關巨噬細胞(TAMs)的協同
SIGLEC15在M2型TAMs上高表達,通過增強TGF-β、IL-10等免疫抑制因子的分泌,加劇局部免疫耐受 [11,12]。同時,其促進血管生成與基質重塑,形成有利于腫瘤轉移的微環境。
3.3 與PD-L1通路的關系
SIGLEC15與PD-L1的表達在不同腫瘤類型中呈互補或獨立特征 [1,4]。高SIGLEC15水平往往伴隨低PD-L1表達和免疫冷微環境,對傳統免疫檢查點抑制劑不敏感 [2]。聯合阻斷兩者可顯著提高免疫治療反應率。
4. SIGLEC15的信號轉導通路
4.1 ITAM/ITIM信號模塊及DAP12介導的激活機制
免疫細胞的信號平衡由激活性ITAM與抑制性ITIM模塊共同調控。盡管SIGLEC15缺乏典型ITIM結構,其跨膜區域具有正電荷殘基,能與含ITAM基序的適配蛋白DAP12結合 [13]。DAP12經Src家族激酶(如Lyn或Fgr)磷酸化后,招募Syk激酶,啟動下游級聯信號,包括PI3K/AKT和MAPK/ERK通路,從而調控細胞激活與分化 [14]。這提示SIGLEC15可在特定環境中轉化為“激活型”調節受體,通過DAP12-Syk軸影響免疫細胞反應。
4.2 Syk/Src激酶通路與免疫調控
Syk家族激酶在免疫信號轉導中居核心地位。SIGLEC15通過DAP12-Syk通路可促進髓系細胞功能改變,增強單核/巨噬細胞的免疫抑制性。部分研究顯示,Syk活化可上調STAT3及NFκB信號,驅動免疫抑制性細胞因子(如IL-10、TGF-β)的表達 [15]。此外,SIGLEC15可能通過Src激酶調節整合素黏附分子活性,影響細胞遷移及免疫突觸形成。
4.3 NFκB與EGFR通路的雙向調控
在白血病和甲狀腺癌研究中發現,NFκB活化可誘導SIGLEC15轉錄上調,從而形成正反饋環路 [7,16]。與此同時,SIGLEC15可與EGFR直接相互作用,穩定其蛋白結構并增強下游ERK和PI3K/AKT信號 [16]。這一機制不僅促進腫瘤細胞遷移與侵襲,也揭示了SIGLEC15在腫瘤進展中的非免疫作用。
總體而言,SIGLEC15信號網絡跨越免疫抑制與促腫瘤通路,通過DAP12-Syk/NFκB/EGFR多軸調控,實現對腫瘤微環境的多層影響。
5. SIGLEC15與相關疾病
SLC3A2作為氨基酸代謝與信號通路的交叉節點,與多種疾病的發生和進展密切相關。
5.1 實體瘤
SIGLEC15在多種實體瘤中高表達,是不良預后的獨立指標。
在HCC中,SIGLEC15通過誘導CD8+ T細胞凋亡促進免疫逃逸,其阻斷可恢復免疫應答 [4]。在膀胱癌中,其高表達與免疫冷微環境形成、免疫治療不敏感及超進展風險增加相關 [2,10]。甲狀腺癌中SIGLEC15高表達與免疫耗竭及侵襲性增強密切相關 [6]。
在膠質瘤中,SIGLEC15水平隨WHO級別升高,與M2型TAMs密切相關,提示其在腦腫瘤免疫微環境重塑中的作用[8]。纖維肉瘤研究顯示,敲低SIGLEC15可顯著減緩腫瘤生長并增強放化療敏感性 [9]。此外,在肺腺癌脊柱轉移 [5]與卵巢癌 [17]中,其高表達亦被證實與侵襲性轉移及免疫逃逸密切相關。
5.2 血液系統惡性腫瘤
在B-ALL中,NFκB信號激活直接上調SIGLEC15轉錄 [7],并促進免疫抑制性細胞因子分泌,削弱T細胞活性。SIGLEC15基因敲除可增強免疫監視并改善白血病微環境。可溶性SIGLEC15在患者血漿中檢測到,提示其有望作為診斷與療效預測的生物標志物。
5.3 骨代謝與炎癥性疾病
SIGLEC15調控破骨細胞分化和骨吸收,是骨穩態的重要因子。研究表明,SIGLEC15在骨微環境中調節RANKL信號傳導,影響破骨細胞形成 [18]。在乳腺癌骨轉移模型中,其可通過抑制CD8+ T細胞活化促進骨轉移形成 [18]。此外,SIGLEC15可能參與類風濕關節炎的炎癥調節,其與DAP12-Syk通路的關聯暗示其在炎性免疫調控中的作用 [13]。
6. 靶向SIGLEC15的藥物研究進展
SIGLEC15作為一種在腫瘤微環境中獨立于PD-L1表達的新興免疫抑制靶點,為克服PD-1/PD-L1耐藥提供了新方向。目前研發以單克隆抗體為主,其中NC-318和PYX-106已分別進入針對非小細胞肺癌和實體瘤的臨床II期與I期,其他多款候選藥物處于臨床前階段;該領域研究不僅探索其單藥潛力,也積極開發與現有免疫療法的聯合方案,并拓展至骨疾病等非腫瘤領域。部分在研管線列舉如下表:
| 藥物 | 作用機制 | 藥物類型 | 在研適應癥(疾病名) | 在研機構 | 最高研發階段 |
|---|---|---|---|---|---|
| NC-318 | Siglec-15抑制劑 | 單克隆抗體 | 晚期非小細胞肺癌 | NextCure, Inc. | 臨床2期 |
| PYX-106 | Siglec-15抑制劑 | ADCC | 單克隆抗體 | 晚期惡性實體瘤 | 實體瘤 | 非小細胞肺癌 | 甲狀腺癌 | Pyxis Oncology, Inc. | 博奧信生物技術(南京)有限公司 | 臨床1期 |
| S15-4E6A | Siglec-15抑制劑 | 生物藥 | 肺腺癌 | 南京醫科大學 | 臨床前 |
| NP-159 | Siglec-15抑制劑 | 單克隆抗體 | 脊髓損傷 | NextCure, Inc. | 臨床前 |
| SHG-8 | Siglec-15抑制劑 | 小分子化藥 | 結直腸癌 | University of Hertfordshire | 臨床前 |
| PBI-108 | PD-1抑制劑 | Siglec-15抑制劑 | 雙特異性抗體 | 實體瘤 | Protheragen, Inc. | 臨床前 |
| BCG-008 | Siglec-15抑制劑 | ADCC | T淋巴細胞刺激劑 | 單克隆抗體 | 實體瘤 | 百奧賽圖(北京)醫藥科技股份有限公司 | 臨床前 |
(數據截止到2025年10月31日,來源于synapse)
7. SIGLEC15研究工具
SIGLEC15作為新型免疫檢查點分子,在腫瘤免疫抑制中扮演核心角色。其信號通路跨越免疫與促腫瘤雙重維度,通過DAP12-Syk、NFκB及EGFR多軸協同調控細胞命運。靶向SIGLEC15的多種治療策略(單抗、雙抗、CAR-T、基因沉默等)正在快速發展,展示出突破PD-1/PD-L1耐藥的潛力。華美生物提供SIGLEC15重組蛋白、抗體、ELISA試劑盒產品,助力您相關機制研究和SIGLEC15靶向藥物研發。
參考文獻:
[1] Weixiang Zhan, F. Bai, Yue Cai, Jianwei Zhang, Ge Qin, Yuqian Xie, Yanhong Deng.(2023). Tumor stroma Siglec15 expression is a poor prognosis predictor in colon adenocarcinoma.
[2] Jiao Hu, Anze Yu, Belaydi Othmane, D. Qiu, Huihuang Li, Chao Li, Peihua Liu, Wenbiao Ren, Minfeng Chen, G. Gong, Xi Guo, Huihui Zhang, Jinbo Chen, X. Zu.(2021). Siglec15 shapes a non-inflamed tumor microenvironment and predicts the molecular subtype in bladder cancer.
[3] Huan Lai, Yiyang Liu, Yan Gong, Chuanyu Zong, Wei Zeng, Honglei Chen.(2024). Expression of SIGLEC15 correlates with tumor immune infiltration, molecular subtypes, and breast cancer progression.
[4] Zheng Chen, Mincheng Yu, Bo Zhang, Lei Jin, Qiang Yu, Shuang-Hu Liu, Binghai Zhou, Jiuliang Yan, Wentao Zhang, Xiaoqiang Li, Yongfeng Xu, Yongsheng Xiao, Jian Zhou, Jia Fan, M. Hung, Qinghai Ye, Hui Li, Lei Guo.(2024). SIGLEC15, negatively correlated with PD-L1 in HCC, could induce CD8+ T cell apoptosis to promote immune evasion.
[5] Haifeng Liang, Lei Zhou, Z. Hu, Yuxiang Ge, Tai-Wei Zhang, Qing Chen, Ben Wang, Shunyi Lu, Wang Ding, J. Dong, Fengfeng Xue, Libo Jiang.(2022). Siglec15 Checkpoint Blockade for Simultaneous Immunochemotherapy and Osteolysis Inhibition in Lung Adenocarcinoma Spinal Metastasis via a Hollow Nanoplatform.
[6] Xiaofeng Hou, Chao Chen, X. Lan, Xiao-dong He.(2022). Unveiling the molecular features, relevant immune and clinical characteristics of SIGLEC15 in thyroid cancer.
[7] Claire E Pillsbury, Jodi Dougan, Jennifer L. Rabe, Jairo A Fonseca, Chengjing Zhou, Alyssa N Evans, Hasan Abukharma, Ona Ichoku, Gloria Gonzalez-Flamenco, Sunita I Park, A. Aljudi, D. DeRyckere, S. Castellino, S. Rafiq, S. Langermann, Linda N. Liu, C. Henry, Christopher C Porter.(2023). Siglec-15 Promotes Evasion of Adaptive Immunity in B-cell Acute Lymphoblastic Leukemia.
[8] Jinchao Wang, Lin-gen Xu, Qian Ding, Xiaoru Li, Kai Wang, Shangchen Xu, Bin Liu.(2023). Siglec15 is a prognostic indicator and a potential tumor-related macrophage regulator that is involved in the suppressive immunomicroenvironment in gliomas.
[9] Juan Wang, Baosheng Li.(2025). Siglec15 as a potential therapeutic target for the treatment of fibrosarcoma.
[10] D. Deng, Jiatong Xiao, Jinhui Liu, Huihuang Li, Minghui Hu, Bohan Zhou, Haisu Liang, Benyi Fan, Jinbo Chen, Xiaogen Kuang, Zhenyu Nie, Jiao Hu, Xiongbing Zu.(2024). Evasion of immunosurveillance by the upregulation of Siglec15 in bladder cancer.
[11] Tianjiao Li, Kaifeng Jin, Hao Li, L. Ye, Pengcheng Li, Bruce Jiang, Xuan Lin, Zhen-Yu Liao, Hui-Ru Zhang, Saimeng Shi, Mengxiong Lin, Qinglin Fei, Zhichun Xiao, Hua-Xiang Xu, Liang Liu, Xianjun Yu, Wei Wu.(2022). SIGLEC15 amplifies immunosuppressive properties of tumor-associated macrophages in pancreatic cancer.
[12] R. Takamiya, K. Ohtsubo, S. Takamatsu, N. Taniguchi, T. Angata.(2013). The interaction between Siglec-15 and tumor-associated sialyl-Tn antigen enhances TGF-β secretion from monocytes/macrophages through the DAP12-Syk pathway.
[13] Xianghong Chen, E. Eksioglu, J. Carter, Nicole R. Fortenbery, Sarah S. Donatelli, Jun-min Zhou, Jinhong Liu, Li-li Yang, D. Gilvary, J. Djeu, Sheng Wei.(2015). Inactivation of DAP12 in PMN Inhibits TREM1-Mediated Activation in Rheumatoid Arthritis.
[14] A. Zarbock, C. Abram, M. Hundt, A. Altman, C. Lowell, K. Ley.(2008). PSGL-1 engagement by E-selectin signals through Src kinase Fgr and ITAM adapters DAP12 and FcRγ to induce slow leukocyte rolling.
[15]Frank Fasbender, M. Claus, S. Wingert, M. Sandusky, C. Watzl.(2017). Differential Requirements for Src-Family Kinases in SYK or ZAP70-Mediated SLP-76 Phosphorylation in Lymphocytes.
[16] Sijing Huang, Zhi Ji, Jinqiang Xu, Yue-ning Yang, Bingrui Wu, Qihang Chen, Shuting Geng, Yu Si, Jiayue Chen, Yuanyan Wei, Cong Wang, Zhilong Ai, Jianhai Jiang.(2023). Siglec15 promotes the migration of thyroid carcinoma cells by enhancing the EGFR protein stability.
[17] T. Ochi, Yuko Matsuoka, Tatsuya Konishi, M. Maruta, Y. Miyazaki, K. Tanimoto, Masaki Yasukawa, Masakatsu Yamashita, Katsuto Takenaka.(2023). Development of a New CAR-T-Cell Therapy Targeting an Immune Checkpoint for Effective Treatment of Solid and Liquid Tumors.
[18] Yutong Wu, Hongbo Ai, Yuhang Xi, Jiulin Tan, Ying Qu, Jianzhong Xu, F. Luo, C. Dou.(2023). Osteoclast-derived apoptotic bodies inhibit naive CD8+ T cell activation via Siglec15, promoting breast cancer secondary metastasis.